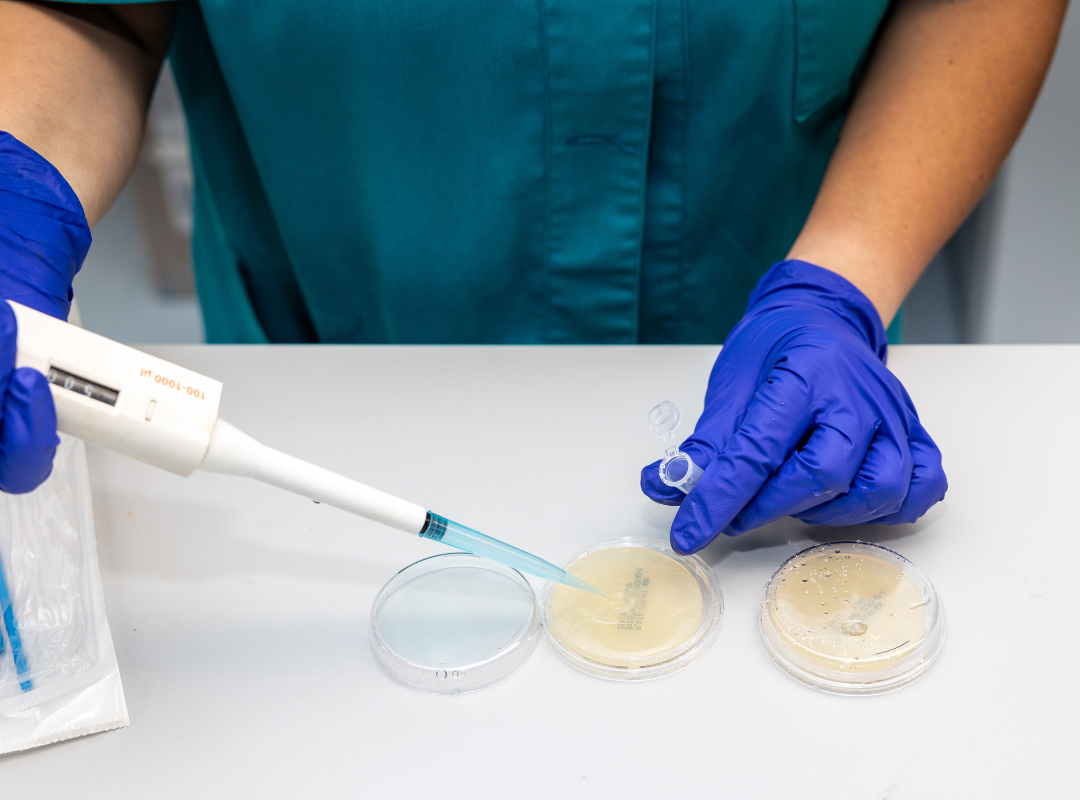

BESCORP HEALTH
Líder en la Elaboración y Distribución
de Complementos Alimenticios en España
Desde la formulación hasta la distribución, garantizamos calidad inigualable en cada paso del proceso.

Con más de 35 años de experiencia, nos encargamos de todo el proceso, desde la creación de fórmulas innovadoras hasta su envasado y distribución. Cada producto que sale de nuestra línea de producción cumple con los más altos estándares de calidad, brindando bienestar y salud a quienes confían en nuestros suplementos.

Certificaciones que avalan nuestro Compromiso con la Calidad
En BESCORP HEALTH, contamos con las certificaciones ISO 9001 y ISO 22000, que respaldan nuestros altos estándares de calidad y seguridad alimentaria.
Estas certificaciones garantizan que nuestros procesos de producción cumplen con las mejores prácticas internacionales, asegurando productos confiables y de calidad para nuestros clientes.
-

Laboratorio
Posee modernas instalaciones con control de temperatura y humedad en todos los recintos, control microbiológico de ambientes y procesos de fabricación totalmente automatizados, contando con análisis propio y registro sanitario.
-

Maquinaria
BESCORP HEALTH posee un parque de maquinaria de los más grandes de España para la fabricación de comprimidos, cápsulas de gelatina dura, viales, fabricación y envasado de líquidos.
-

Importación
Importamos gran parte de las materias primas por contenedores directamente de los fabricantes de Estados Unidos, Canadá, Chile, Japón, Europa, etcétera. Sólo así, se puede garantizar la mejor calidad de la materia prima y el mejor precio.

En Bescorp Health, nos enorgullece ser el proveedor de confianza para numerosas marcas en España y a nivel internacional. Fabricamos para una amplia variedad de clientes, desde pequeños comerciantes con marcas propias, hasta distribuidoras nacionales de farmacia como Hefame (Interapothek), así como grandes superficies de prestigio como El Corte Inglés.

A nivel internacional, hemos establecido una fuerte presencia en Portugal, donde fabricamos para algunas de las marcas líderes del país, distribuidas en todas las grandes superficies. También exportamos nuestros productos a China, Tailandia, Vietnam, Singapur, Taiwan, Hong Kong, Macao y Países Bálticos donde el producto europeo es altamente valorado, y estamos en plena expansión en mercados clave como: Países Árabes, Marruecos, Inglaterra o Estados Unidos.
Además, BESCORP HEALTH es propietaria de distintas marcas líderes como Sotya Health Supplements, Beslan Healthy Pets y GHF (General Health Food) que se comercializan con éxito en distintos países del mundo, consolidándose como un referente en el sector.